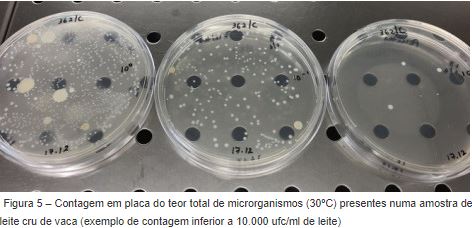

Contagens de células somáticas e de microrganismos a 30ºC
O leite constitui o primeiro alimento na vida dos mamíferos e é um dos alimentos mais completos, dada a sua riqueza nutricional e versatilidade em termos de utilização.
O leite é composto por 80 a 90% de água e os restantes 10 a 20% consistem numa mistura de componentes complexos, como proteínas, carboidratos, gordura, minerais e vitaminas.
A composição química do leite é diferente, consoante a espécie de mamífero, e varia diariamente de acordo com uma determinada raça, dependendo também do estado de lactação, idade e nutrição desta, da estação do ano e da temperatura ambiental, entre outros fatores.
As características de um leite de qualidade elevada são, entre outras: ausência de microrganismos patogénicos, ausência de sedimentos ou outro material contaminante, ausência de odores e sabores estranhos, contagens baixas de células somáticas, sabor ligeiramente doce, nenhum odor distinto, cumprimento com os requisitos legais em termos de concentrações mínimas de gordura, sólidos totais e outros sólidos que não gordura.
A composição e a qualidade do leite na natureza podem, contudo, sofrer grandes alterações devido a muitos fatores.

Uma das causas mais importantes e que provoca profundas alterações na composição do leite é a mastite (figura 1), uma inflamação das glândulas mamárias do gado, causada maioritariamente por bactérias e pelas suas toxinas, acompanhada de um aumento no número de células somáticas que são eliminadas no leite.

As células somáticas incluem as células epiteliais libertadas do revestimento da glândula mamária bem como os leucócitos que entraram na glândula como resposta a uma infeção ou dano na mesma (figura 4).

A mastite ou uma contagem de células somáticas (doravante denominada CCS) elevada está associada a um decréscimo nas concentrações de lactose, α-lactalbumina e gordura no leite, a tempos de prateleira menores e a alterações nas características organoléticas do mesmo, sendo que a produção posterior de queijo, iogurtes ou outros derivados é afetada pela presença dessas células no leite (Sharma et al., 2011).
As células somáticas são indicadoras da resistência ou da suscetibilidade dos animais à mastite e a sua contagem pode ser usada para monitorizar o nível ou a ocorrência de mastite subclínica em manadas ou num determinado animal. Na mastite subclínica não ocorrem alterações visíveis na aparência do leite ou da glândula mamária, mas a produção de leite diminui, a composição do mesmo encontra-se alterada, estando presentes bactérias.

Existem diversos fatores, citados por Sharma et al. (2011) e Müller (2002), que podem afetar o número de células somáticas presentes no leite, nomeadamente:
- o nível de infeção da glândula mamária;
- fase de lactação (a contagem de células somáticas aumenta com o progresso da lactação, estando associada a uma resposta imunitária inata do organismo aquando da preparação para o parto);
- idade/raça (existe uma prevalência de infeções em animais mais velhos, com o consequente aumento da CCS);
- estação do ano (a CCS é normalmente mais baixa durante o Inverno e superior no Verão);
- variação diurna (estudos têm demonstrado que entre duas ordenhas consecutivas da mesma vaca, a CCS pode variar cerca de 30% ou até mesmo mais de 40%);
- gestão do leite (condições de fraca higiene aumentam consideravelmente a probabilidade de infeções intra-mamárias, resultando em CCS elevadas).
A contagem de microrganismos a 30ºC (figura 5) realizada a uma amostra de leite fornece, por sua vez, uma indicação do teor geral de microrganismos presentes nessa amostra.
O leite cru, tal como é excretado das glândulas mamárias de animais saudáveis, contém normalmente, números muito baixos de microrganismos (< 1.000 ufc/ml). Tipicamente, a flora natural do animal não irá influenciar as contagens de coliformes ou de microrganismos a 30ºC, contudo, pode ocorrer a contaminação bacteriana do leite cru a partir de pelo menos três fontes: interior do úbere da vaca, exterior do úbere e tetas, e superfície do equipamento e utensílios de ordenha, armazenamento e transporte do leite.
O leite proveniente de animais com infeções é automaticamente impróprio para o consumo humano pois esse leite pode representar um mecanismo de transmissão de doenças como a tuberculose, brucelose, leptospirose, entre outras.
O leite pode também sofrer contaminação bacteriana entre ordenhas quando as tetas das vacas contactam com a água, solo, material do leito ou pasto.
A lavagem e limpeza das tetas antes e após a ordenha reduz significativamente o número de organismos patogénicos ambientais causadores de mastites e o grau de limpeza do sistema de ordenha é provavelmente o fator que mais influencia a contagem total de bactérias no leite cru (Wallace, 2008).
Crê-se que os organismos considerados como pertencentes à flora natural do canal e da pele da teta do animal não crescem de forma significativa nas superfícies sujas. Em termos gerais, bactérias provenientes de contaminações ambientais (estrume, material do leito e pasto dos animais, entre outros) são mais propensas de se desenvolver em superfícies sujas.
Os procedimentos de limpeza e higienização podem influenciar o grau e tipo de crescimento bacteriano nas superfícies que contactam com o leite pois podem deixar resíduos neste que promovam o crescimento de determinados microrganismos.
Uma limpeza menos eficiente, usando temperaturas mais baixas e/ou a ausência de detergentes, tende a selecionar os organismos que crescem mais rapidamente e que são menos resistentes, especialmente bacilos Gram negativos (coliformes e Pseudomonas) e alguns estreptococos (Wallace, 2008).
A pasteurização reduz o número de microrganismos patogénicos presentes no leite, mas não inibe os efeitos prejudiciais das toxinas produzidas por alguns desses microrganismos. Embora seja impossível eliminar todas as fontes de contaminação, contagens inferiores a 10.000 ufc/ml deveriam ser atingidas pela maior parte dos produtores.
O regulamento (CE) n.º 853/2004 que estabelece regras específicas de higiene aplicáveis aos géneros alimentícios de origem animal determina (secção IX: Leite cru, colostro, produtos láteos e produtos à base de colostro) que os operadores das empresas do setor alimentar devem proceder de forma a assegurar que o leite cru de vaca obedece aos seguintes critérios:
– Contagem em placas a 30 °C (por ml) ≤ 100.000 (*)
– Contagem de células somáticas (por ml) ≤ 400.000 (**)
em que:
(*) é a média geométrica constatada ao longo de um período de dois meses, com, pelo menos, duas colheitas mensais.
(**) é a média geométrica constatada ao longo de um período de três meses, com, pelo menos, uma colheita mensal, a não ser que a autoridade competente especifique outra metodologia para atender às variações sazonais nos níveis de produção.
Quanto ao armazenamento, a maioria dos microrganismos presentes no leite reproduz-se à temperatura de 37ºC, ou seja, à mesma temperatura do leite recém-ordenhado. Como tal, o leite deve ser refrigerado o mais rapidamente possível após a ordenha.
O regulamento acima referido estabelece que o leite, imediatamente após a ordenha, deve ser arrefecido imediatamente, não excedendo os 8 °C (no caso da recolha ser feita diariamente) ou os 6 °C (caso a recolha não seja feita diariamente) e que, durante o transporte, à chegada ao estabelecimento de destino, a temperatura do leite não deverá ser superior a 10 °C.
Referências
Müller, E. (2002), Qualidade do Leite, Células Somáticas e Prevenção da Mastite, Anais do II Sul-Leite: Simpósio sobre Sustentabilidade da Pecuária Leiteira na Região Sul do Brasil, 206-217
Phibro – Animal Health Corporation (2020), Mastitis in dairy cows. Última vez consultado a 26/09/2020 em europe.pahc.com/challenges/mastitis
Sharma, N.; Singh, N. e Bhadwal, M. (2011), Relationship of Somatic Cell Counts and Mastitis: An Overview, Asian-Australasian Journal of Animal Science, 24(3):429-438
Wallace, R. (2008), Bacteria Counts in Raw Milk. Última vez consultado a 26/9/2020 em http://www.livestocktrail.illinois.edu/dairynet/paperDisplay.cfm?ContentID=9957
Zajác, P. (2017), Somatic Cells Stained with NL-LW Staining Solution. Última vez consultado a 26/9/2020 em https://commons.wikimedia.org/wiki/File:Somatic_cells_stainied_with_NL-LW_staining_solution_.jpg
Ana Campos
Técnica Superior
Fonte: DICAs



